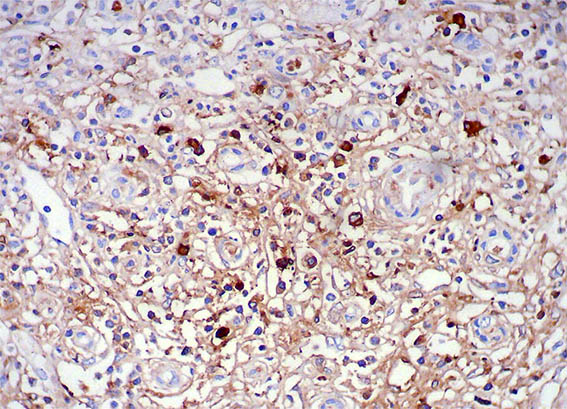

|
|
CASE
185 (July 2021)
Clinical information
The patient is a 38-year-old man, he presents constitutional symptoms of 6 months of evolution, weight loss, approximately 10 kg, intermittent fever, predominantly nocturnal, and progressive elevation of serum creatinine, with a recent abrupt elevation up to 8 mg/dL, requiring dialysis.
Negative autoimmunity studies, except for a mild decrease in C3 serum levels: 84 mg/dL (90-180), C3: 20.2 (12-40), with negative ANAs and anti-DNA. Normal liver biochemistry. Negative virus studies. PTH: 110 pg/mL, APS profile: negative. Electrophoresis without monoclonal peak. LDH: normal; erythrocyte sedimentation rate (ESR): 120 mm/h. By ultrasound: enlarged kidneys, with poor corticomedullary differentiation. Proteinuria: 700 mg/24h, in the sediment 3 erythrocytes/hpf, leukocytes: 6/hpf. Inguinal, periaortic, and retroperitoneal lymph nodes are documented.
Kidney biopsy is done. Look at the pictures.

Figure 1. H&E, X100. Note the prominent tubulointerstitial involvement.

Figure 2. H&E, X200.

Figure 3. H&E, X400. Interstitial infiltrate of lymphocytes, neutrophils, eosinophils, and plasma cells.

Figure 4. H&E, X400.

Figure 5. H&E, X400.

Figure 6. PAS, X400. Notorious fibrosis and tubular atrophy.

Figure 7. Methenamine-silver stain, X100.

Figure 8. Methenamine-silver stain, X400. Glomeruli with normal characteristics.

Figure 9. Immunohistochemistry for IgG, X200. Abundant IgG positive plasma cells, many of them IgG4: see images 11 and 12.

Figure 10. Immunohistochemistry for IgG, X400.
Figure 11. Immunohistochemistry for IgG4, X200.

Figure 12. Immunohistochemistry for IgG4, X400.
Direct immunofluorescence for IgA, IgG, IgM, C3, C1q, kappa and lambda: Negative in glomeruli, basal tubular and interstitium.
What is your diagnosis?
See
diagnosis and discussion
[Top]
|
|